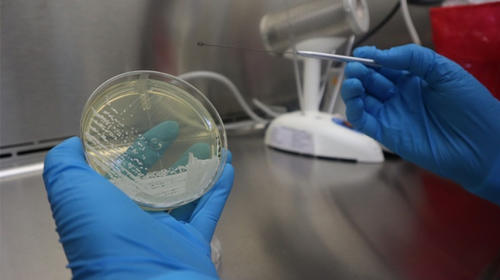
Alerta por Candida Auris: un peligroso hongo detectado en el país

Los diputados guardaron un minuto de silencio este miércoles en memoria de Sharon Jasmine Figueroa Arriaza, una niña de ocho años que fue localizada sin vida, luego de que su familia la reportó como desaparecida.
EN CONTEXTO: Localizan sin vida a Sharon, la niña desaparecida en Petén
Horas después de que se supo del asesinato, el legislador de la Unidad Nacional de la Esperanza (UNE), César Fión, le pidió a sus colegas guardar el minuto de silencio.
"Exigimos justicia para el pueblo petenero, para el pueblo de Melchor de Mencos. Estamos exigiendo que paren los asesinatos", señaló Fión.
Sharon desapareció el martes mientras jugaba con su bicicleta en el patio de su casa en el Barrio La Ceibita de Melchor de Mencos, Petén. La noche de este martes, agentes de la Policía Nacional Civil (PNC), vecinos y familiares de Sharon iniciaron una búsqueda en el área y encontraron la bicicleta y la ropa de la menor.
Este miércoles, el cadáver de Sharon fue localizado a 500 metros de una escuela abandonada en el caserío Camalote de Melchor de Mencos.
Por este caso, el Ministerio Público (MP) reporta una captura. Según las autoridades, Sonia Esperanza González Cho podría tener vínculos con el crimen porque en su vivienda encontraron " indicios que podrían vincular a la detenida con la desaparición de la niña" y trasladaron estos objetos al Instituto Nacional de Ciencias Forenses (Inacif) para su evaluación.
- MIRA AQUÍ: